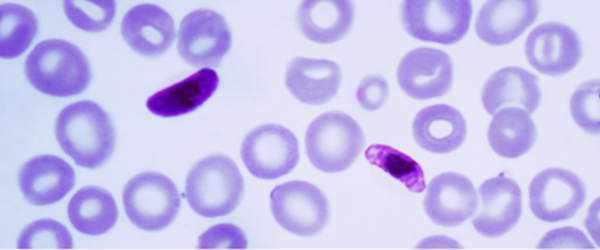

Protozoários e protozooses
O que são protozoários?

Protozoários e protozooses
O que são protozoários?
Como foram descobertos?
Protozoários são inicialmente classificados por Goldfuss em 1818 como um filo - Filo Protozoa - pertencente ao Reino Animal.
Por falta de conhecimento suficiente e se pensar que eram muito semelhantes aos animais, a nomenclatura adotada na época remontava justamente aos "primeiros animais" - do latim Proto (primeiro) e Zoa (animal).
O verdadeiro crescimento conhecimento relacionado a tais microorganismos se deu no final do século XIX e início do século XX, sobretudo após as pesquisas de Koch e Pasteur.
Inúmeros estudos relacionados à epidemiologia das doenças - bem com o seu ciclo de vida e os parasitas a elas relacionados - começaram a despertar interesse total da comunidade científica, desenvolvendo, assim, o atual Filo Protista.
| Doença | Cientista marcante | Data de descobrimento |
|---|---|---|
| Leishmaniose | Cunningham e Leishmaniose | 1885 (Índia) e 1903 (Reino Unido), respectivamente |
| Malária | Aphone Laveran | 1881 (França) |
| Chagas | Carlos Chagas | 1909 (Brasil) |





Carlos Chagas

Quais são as suas principais características?
| Eucariotos |
| Unicelulares |
| Heterótrofos |
| Mobilidade especializada |
| Tamanho bastante reduzido |
| Vida livre ou parasitária |
| Variados ambientes e estilos de vida |
| Organelas específicas (alguns) |
| Alimentação: fagocitose |
| Reprodução: divisão binária ou múltipla |
Protozoários são microorganismos pertencentes a um grupo polifilético - o reino Protista -, que une diferentes organismos que não se encaixam no reino Metazoa. As algas fazem parte do mesmo reino.
São classificados em 4 grupos de acordo com o seu meio de locomoção:
1. Ciliados;
2. Flagelados;
3. Rizópodos; e
4. Esporozoários.


Estrutura celular


É possível a visualização de organelas e estruturas específicas.
As estruturas variam de acordo com a classe específica de protozoários.
Obrigado e até a próxima aula!

Protozoários e protozooses
Doença de Chagas
Características gerais
Doença tropical parasitária causada pelo protozoário Trypanosoma cruzi e transmitida, principalmente, por insetos da subfamília Triatominae - onde está incluído o barbeiro.
Geralmente apresenta duas fases, a aguda e a crônica. Na fase inicial (aguda), sintomas podem ser ausentes ou típicos de uma infecção, como gânglios linfáticos aumentados, febre e dor de cabeça. Na fase crônica (que pode durar a vida toda), são manifestados a maioria dos sintomas característicos, de forma bem gradual, como cardiomegalia e megacólon.
| Agente etiológico: Trypanosoma cruzi |
| Vetor de transmissão: Inseto barbeiro (Triatoma infestans) |
Todos os estágios de desenvolvimento do barbeiro têm a possibilidade de transmissão do protozoário.



Ciclo da doença
O ciclo da doença se inicia com a picada do barbeiro e subsequente evacuação no mesmo local. Os tripanossomas contidos nas fezes do inseto entrarão na corrente sanguínea sob a forma de tripomastigotas, onde se transformarão em amastigotas, causando danos teciduais.

| Hospedeiro intermediário: Inseto barbeiro |
| Hospedeiro definitivo: Mamífero (ser-humano) |
| Estágios celulares |
| Tripomastigotas ᐅ Amastigotas ᐅ Tripomastigotas ᐅ Epimastigotas |

Ciclo (desenvolvimento) do vetor
Os barbeiros são insetos hematófagos cujos jovem e adultos, fêmeas e machos, alimentam-se exclusivamente de sangue de animais vertebrados.
| Estágios de desenvolvimento |
| Ovos ᐅ Ninfas ᐅ Barbeiro em crescimento |

Podem se esconder em frestas de paredes de casas, camas, colchões e móveis (no geral), mas são predominantemente presentes em casas de pau a pique.

Profilaxia e tratamento
| Controle dos vetores |
| Uso de inseticidas |
| Melhora das condições habitacionais |
| Garantia de educação e informação |
| Precauções |
| Transfusões sanguíneas adequadas |
| Segurança alimentar (caldo de cana e açaí) |
| Manutenção do habitat do barbeiro |


Obrigado e até a próxima aula!

Protozoários e protozooses
Malária
Características gerais
Doença infecciosa causada por um protozoário do gênero Plasmodium e transmitida por um mosquito fêmea infectado do gênero Anopheles. Os sintomas típicos da malária são os ataques paroxísticos, em que há a presença de muitos calafrios, febres que têm períodos de tempo delimitados, icterícia e dores nas articulações.

É uma infecção endêmica de regiões tropicas e subtropicais devido à chuva abundante, temperatura quente e grande quantidade de água estagnada, estando mais presente na faixa da Terra próxima à linha do equador.
| Agente etiológico: Protozoário do gênero Plasmodium |
| Vetor de transmissão: Mosquito do gênero Anopheles |
Ciclo da doença
1. O mosquito Anopheles inocula os esporozoítos dentro do homem mediante a picada. Logo após, hepatócitos são invadidos pelos parasitas, onde começarão a se reproduzir.
2. Toda essa reprodução origina milhares de merozoítos, que caem na corrente sanguínea e invadem eritrócitos, iniciando novas divisões.
3. Podem, a partir daí, romper as hemácias e liberar mais merozoítos ou desenvolverem-se em gametócitos.
4. Esses gametócitos serão liberados na corrente sanguínea e transferidos para o mosquito por meio do sangue no ato da
picada, dando início ao ciclo novamente.

| Hospedeiro intermediário: Mamífero (ser-humano) |
| Hospedeiro definitivo: Mosquito Anopheles |
| Tipo de ciclo: Heteroxênico e esquizogônico |
| Fases: Ciclo pré-eritrocítico e eritrocítico |
| Estágios celulares |
| Esporozoítos ᐅ Merozoítos ᐅ Gametócitos ᐅ Esporozoítos |
Ciclo (desenvolvimento) do vetor
1. O desenvolvimento do mosquito terá 4 fases: ovo, larva, pupa e adulto.
2. Tudo se inicia mediante a deposição dos ovos em algum ambiente aquático por parte da fêmea. Os ovos eclodem, dando origem às larvas.
3. Após 4 ecdises, as larvas se convertem em pupas, onde continuam se desenvolvendo até atingir a fase adulta.
4. Enfim atingida a última fase, o mosquito descansa por um tempo, de modo a amadurecer e enrijecer as suas estruturas, e voa em busca do acasalamento, dando inicio ao ciclo.


Profilaxia e tratamento

| Controle dos vetores |
| Uso de inseticidas e repelentes |
| Melhora das condições habitacionais |
| Uso de mosquiteiros nas camas |
| Precauções |
| Evitar acúmulo de água |
| Uso de quimioprofiláticos |
| Desenvolvimento de vacina |
Obrigado e até a próxima aula!

Protozoários e protozooses
Leishmaniose
Características gerais
A leishmaniose é uma doença infecciosa causada por protozoários do gênero Leishmania, transmitidos pela picada de insetos da subfamília dos Flebotomíneos. Existem 3 tipos de leishmaniose: cutânea, mucocutânea e visceral, sendo as úlceras presentes na pele e em órgão específicos o grande sintoma determinador dessas condições.



As espécies Leishmania braziliensis (causadora do tipo mucocutânea), bem como a Leishmania donovani (causadora do tipo visceral) são as mais famosas.



Ciclo da doença
1. Tudo tem início com a inoculação de promastigotas metacíclicos (estágio infeccioso) mediante a picada de mosquitos flebotomíneos.
2. Uma vez presentes na circulação sanguínea, os promastigotas são fagocitados pelos macrofagos e outras células do sistema imune.
3. Uma vez dentro dessas células, os promastigotas se desenvolvem em amastigotas (estágio tecidual), que são liberados pela ruptura do macrófago, causando os danos teciduais específicos.
4. Ao se alimentar do sangue do hospedeiro, o mosquito é contaminado por macrófagos com amastigotas no seu interior, dando início ao ciclo novamente.



| Hospedeiro intermediário: Mamífero (ser-humano ou cão) |
| Hospedeiro definitivo: Mosquito flebotomíneo |
| Tipo de ciclo: Heteroxênico |
| Fases: Estágio infeccioso e estágio tecidual |
| Estágios celulares |
| Promastigotas ᐅ Amastigotas |
Ciclo (desenvolvimento) do vetor
Flebotomíneos apresentam desenvolvimento indireto e metamorfose completa, tendo 4 fases distintas no seu ciclo de vida: ovo, larva, pupa e inseto adulto.
As pupas não necessitam de um grau de umidade muito elevado (o que não acontece com os ovos e as larvas).

As fêmeas adultas colocam os ovos em ambientes propícios, como terra úmida ou regiões nas proximidades de córregos, cursos de água ou lagos.



Profilaxia e tratamento
Para evitar os riscos de transmissão, algumas medidas de proteção individual devem ser estimuladas, tais como: uso de mosquiteiro com malha fina, telagem de portas e janelas, uso de repelentes, não se expor nos horários de atividade do vetor (crepúsculo e noite) em ambiente onde este habitualmente pode ser encontrado.

| Controle dos vetores |
| Uso de inseticidas e repelentes |
| Melhora das condições de higiene e tratamento de lixo |
| Limpeza de regiões com muito acúmulo de matéria orgânica |
| Precauções |
| Vacinação dos animais de estimação (cachorros) |
| Controlar exposição de cachorros domésticos à rua em horários de risco |
Infelizmente, a leishmaniose canina permanece sem cura total. Para os seres humanos, o tratamento é encontrado no SUS de forma gratuita.
Obrigado e até a próxima aula!

Protozoários e protozooses
Giardíase e Amebíase
Características gerais
A giardíase é uma doença parasitária causada pela Giardia duodenallis, enquanto a amebíase é causada por qualquer um dos parasitas amebóides do gênero Entamoeba - sendo os sintomas mais comuns os de diarréia, dores abdominais, perda de peso e fezes com sangue (nos casos mais graves).
Ambas as infecções parasitárias têm a mesma forma de transmissão: ingestão de água ou alimentos contaminados com cistos do parasita, podendo ser transmitidos de pessoas para pessoas ou de animais para pessoas.




Ciclo da doença (amebíase)
1. O ciclo se inicia mediante a ingestão de água ou alimentos contaminados com cistos do parasita.
2. Uma vez dentro do organismo, o cisto se abre, liberando trofozoítos no intestino delgado, que se desenvolvem e migram para o intestino grosso.
3. Os trofozoítos começam a se reproduzir, invadindo, assim, a mucosa intestinal e adentrando a corrente sanguínea.

4. Por meio da corrente sanguínea, chegam a outros órgãos, causando lesões teciduais.
5. Por fim, convertem-se em cistos por meio do enquistamento, podendo ser liberados para o exterior por meios das fezes.


Ciclo da doença (giardíase)
O ciclo da giardíase é exatamente o mesmo da amebíase, diferindo apenas o protozoário.

Profilaxia e tratamento


| Controle de transmissão |
| Saneamento básico |
| Tratamento dos infectados |
| Segurança alimentar (lavagem correta dos alimentos) |
| Hábitos de higiene pessoais |
| Eliminação de moscas e baratas |
| Tratamento |
| Ingestão de líquidos (para barrar a desidratação) |
| Antiparasitários específicos |
| Repouso |

Obrigado e até a próxima aula!

Protozoários e protozooses
Bônus: aulinha de toxoplasmose
Características gerais
A toxoplasmose é uma doença parasitária causada pelo protozoário Toxoplasma gondii, sendo geralmente transmitida por via da ingestão de alimentos mal-cozinhados que contenham cistos do parasita, exposição a fezes de gato contaminadas ou de mãe para o filho durante a gravidez.
Os bradizoítos presentes no interior dos cistos dizem respeito à forma infectante do parasito.




| Agente etiológico: Toxoplasma gondii |
| Modo de transmissão: Cistos livres ou em tecido de carne mal-cozida |
Ciclo da doença
1. Tudo tem início com a contaminação dos felinos mediante a ingestão de carne contaminada com cistos em seus tecidos.
2. No tubo digestório, os cistos rompem-se, liberando os bradizoítos que estavam no seu interior.
3. Os bradizoítos invadem a mucosa do intestino, diferenciando-se e reproduzindo-se.
4. Oocistos são liberados nas fezes dos animais, contaminando o ambiente.
5. Por meio do consumo de tecidos contaminados ou ingestão indireta, o homem é contaminado. O oocisto libera os esporozoítos ou bradizoítos - a depender do meio de contaminação -, que rapidamente se convertem em taquizoítos quando invadem células nucleadas, degradando o tecido.
| Hospedeiro intermediário: Aves e mamíferos (ser-humano) |
| Hospedeiro definitivo: Felinos (gato doméstico) |
| Tipo de ciclo: Heteroxênico |
| Estágios celulares |
| Ooscitos ᐅ Esporozoítos ᐅ Taquizoítos ᐅ Bradizoítos |

Profilaxia e tratamento
| Controle de transmissão |
| Consumo de carne bem cozida |
| Tratamento dos infectados e cuidado especial com felinos |
| Segurança alimentar (lavagem correta dos alimentos) |
| Hábitos de higiene pessoais |
| Eliminação de moscas e baratas |
| Tratamento |
| Utilização de antibióticos e antiparasitários específicos |



Protozoários e protozooses
By guiadabiologia
Protozoários e protozooses
- 112